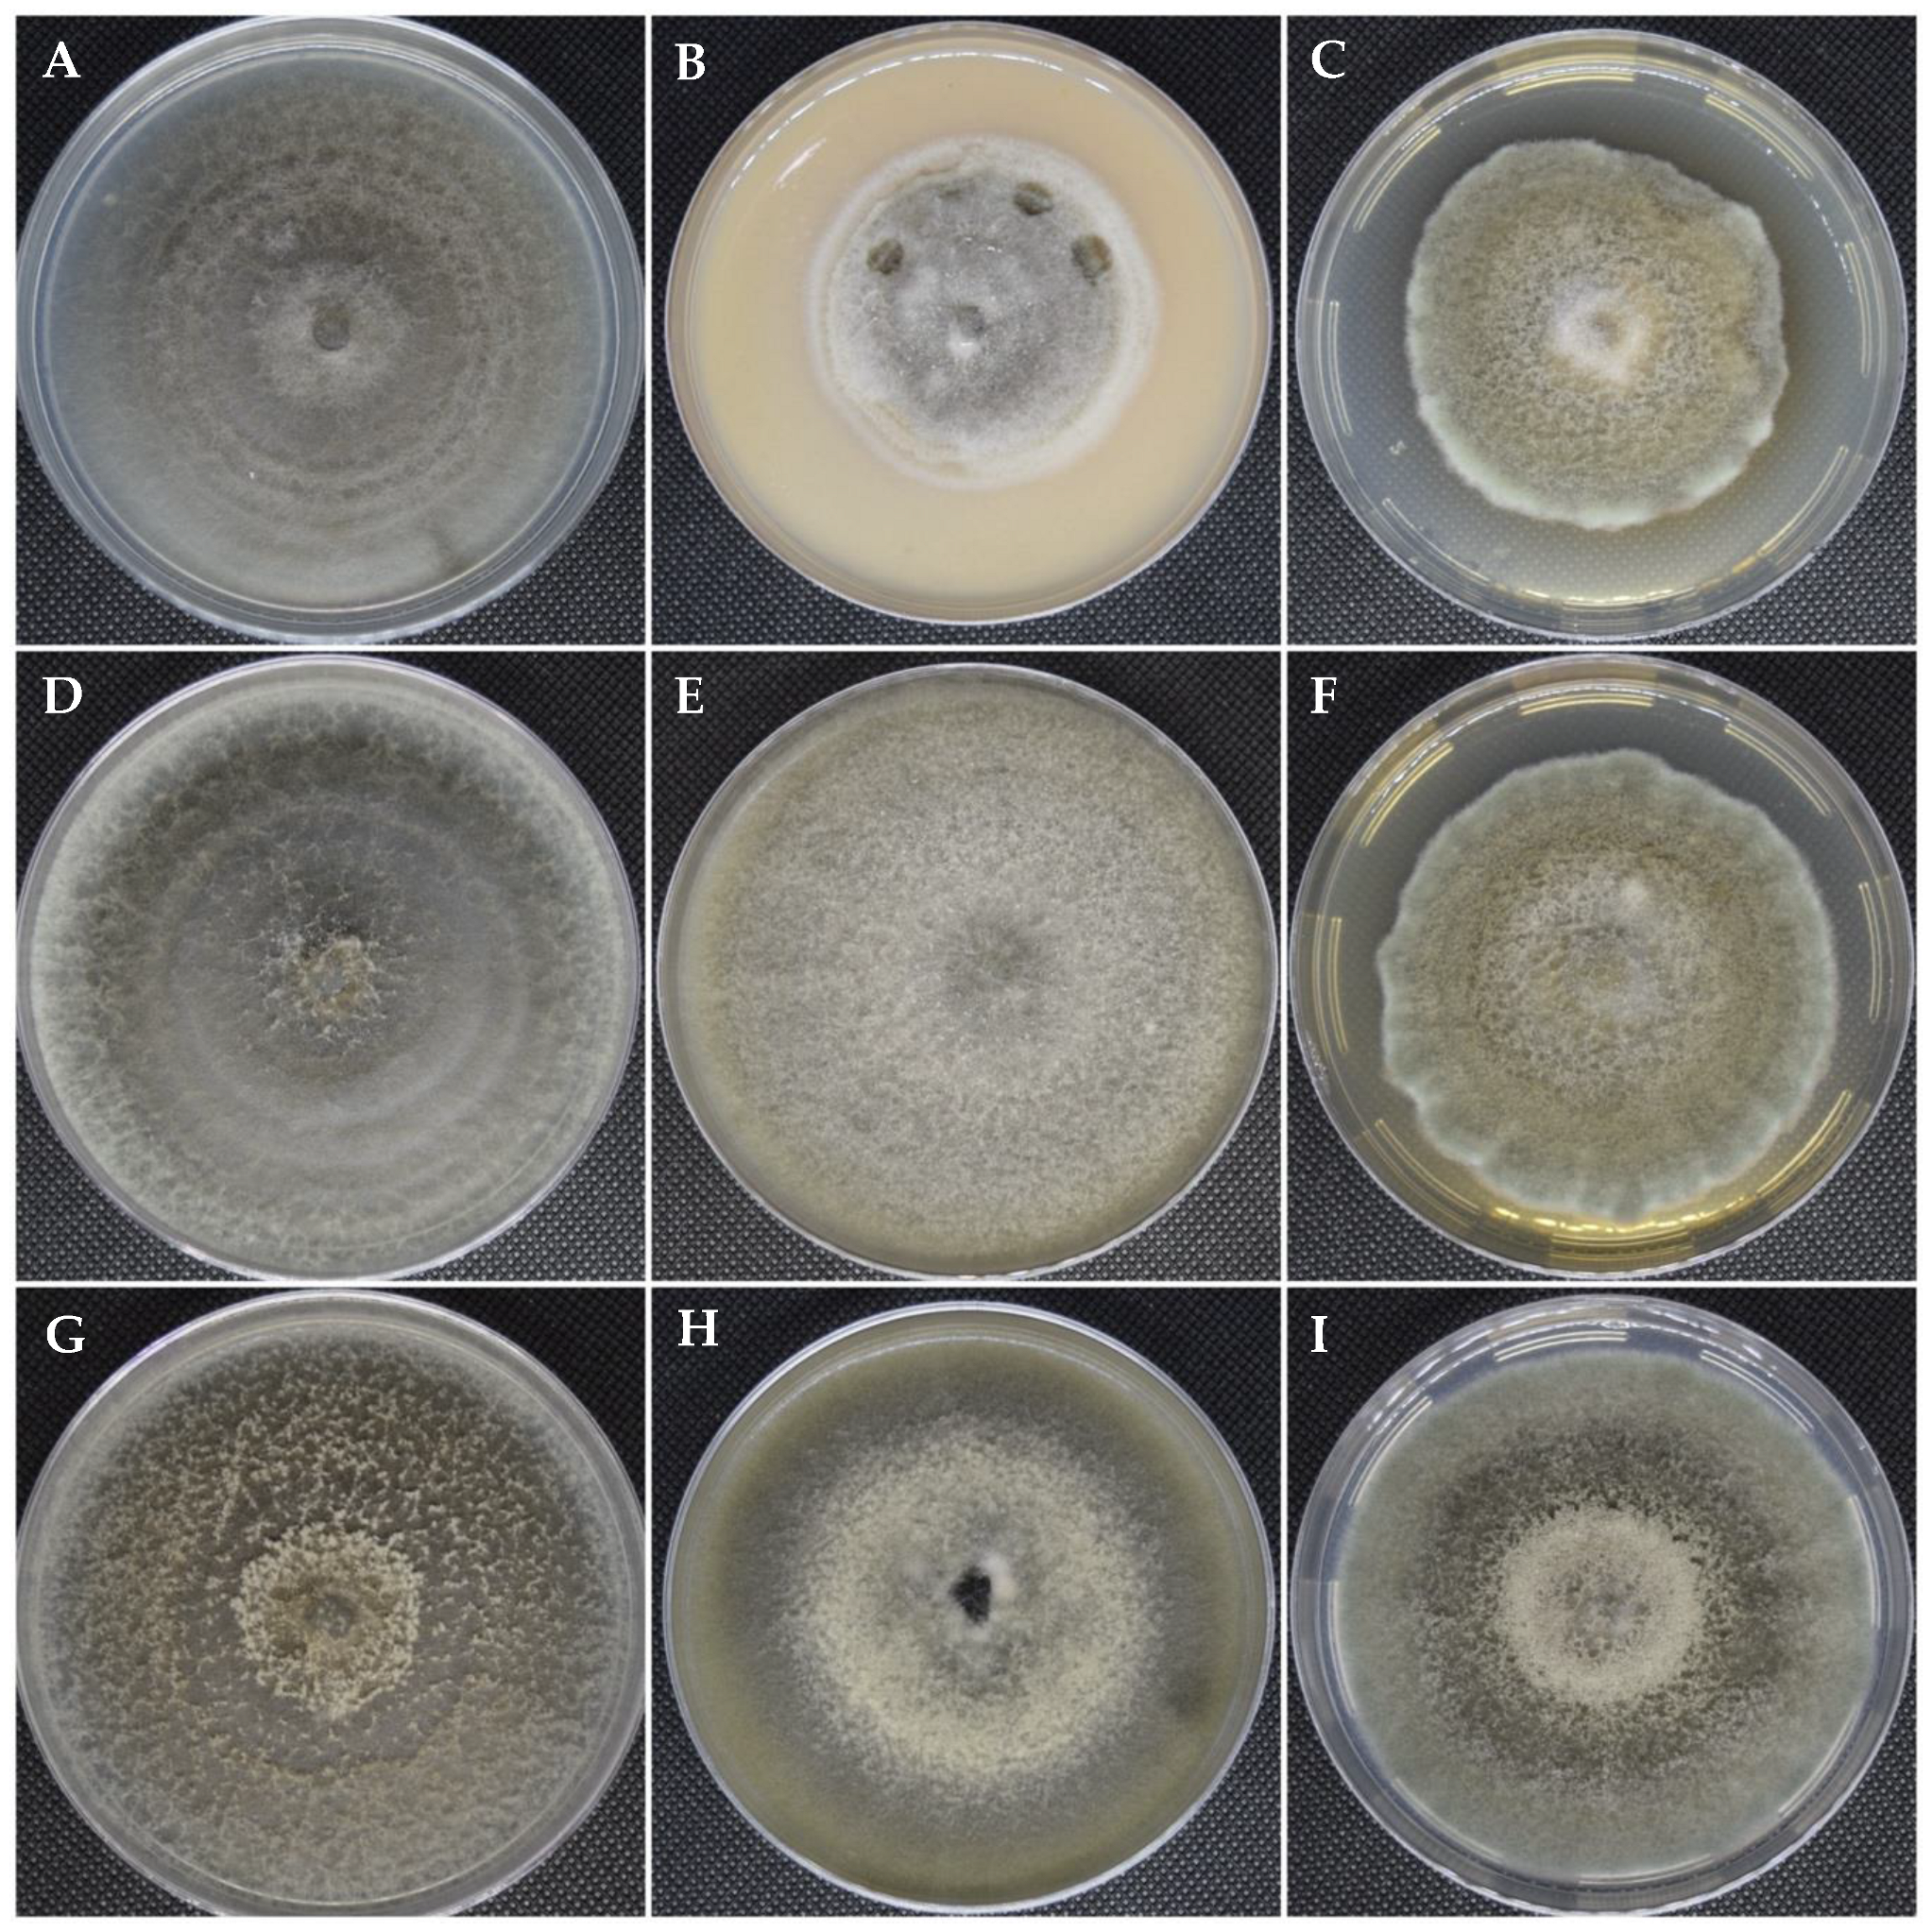
Microorganisms 12 01714 g001

Etiology of Foliar Blight of Indian Paintbrush (Castilleja tenuiflora) in Mexico
Abstract
1. Introduction
2. Materials and Methods
2.1. Sample Collection, Isolation, Purification, and Preservation of the Fungus Associated with Indian Paintbrush Leaf Blight
2.2. Cultural and Morphological Characterization
2.3. DNA Extractions
2.4. Polymerase Chain Reactions (PCR) and Sequencing
2.5. Identification by Phylogenetic Reconstruction
2.6. Pathogenicity Tests
3. Results
3.1. Cultural and Morphological Characterization
3.2. Phylogenetic Identification
3.3. Pathogenicity Tests
4. Discussion
5. Conclusions
Author Contributions
Funding
Data Availability Statement
Conflicts of Interest
References
- Aguilar, A.; Camacho, J.; Chino, S.; Jacquez, P.; López, M. Herbario Medicinal del Instituto Mexicano del Seguro Social. In Información Etnobotánica; México, D.F., Ed.; Mexican Social Security Institute: Torreón, Mexico, 1994. [Google Scholar]
- Martínez, M. Catálogo de Nombres Vulgares y Científicos de Plantas Mexicanas; México, D.F., Ed.; Fondo de Cultura Económica: Distrito Federal, México, 1979. [Google Scholar]
- Moreno-Escobar, J.A.; Bazald, A.S.; Villarreal, M.L.; Bonilla-Barbosa, J.R.; Mendoza, S.; Rodríguez-López, V. Cytotoxic and antioxidant activities of selected Lamiales species from Mexico. Pharm. Biol. 2011, 49, 1243–1248. [Google Scholar] [CrossRef]
- Monroy-Ortiz, C.; Castillo-España, P. Plantas Medicinales Utilizadas en el Estado de Morelos; Comisión Nacional para el Conocimeinto y Uso de la Biodiversidad: Tlalpan, Mexico; Universidad Autonoma del Estado de Morelos: Cuernavaca, Mexico, 2007. [Google Scholar]
- Béjar, E.; Reyes-Chilpa, R.; Jiménez-Estrada, M. Bioactive Compounds from Selected Plants used in the XVI Century Mexican Traditional Medicine. Stud. Nat. Prod. Chem. 2000, 24, 799–844. [Google Scholar]
- Carrillo-Ocampo, D.; Bazaldúa-Gómez, S.; Bonilla-Barbosa, J.R.; Aburto-Amar, R.; Rodríguez-López, V. Anti-inflammatory activity of iridoids and verbascoside isolated from Castilleja tenuiflora. Molecules 2013, 18, 12109–12118. [Google Scholar] [CrossRef] [PubMed]
- Alonso-Castro, A.J.; Villarreal, M.L.; Salazar-Olivo, L.A.; Gomez-Sanchez, M.; Dominguez, F.; Garcia-Carranca, A. Mexican medicinal plants used for cancer treatment: Pharmacological, phytochemical and ethnobotanical studies. J. Ethnopharmacol. 2011, 133, 945–972. [Google Scholar] [CrossRef]
- Graham, J.G.; Quinn, M.L.; Fabricant, D.S.; Farnsworth, N.R. Plants used against cancer—An extension of the work of Jonathan Hartwell. J. Ethnopharmacol. 2000, 73, 347–377. [Google Scholar] [CrossRef] [PubMed]
- Hirschhorn, H.H. Botanical remedies of south and central america, and the caribbean: An archival analysis. part II. conclusion. J. Ethnopharmacol. 1982, 5, 163–180. [Google Scholar] [CrossRef]
- López-Rodríguez, R.; Herrera-Ruiz, M.; Trejo-Tapia, G.; Domínguez-Mendoza, B.E.; González-Cortazar, M.; Zamilpa, A. In Vivo Gastroprotective and Antidepressant Effects of Iridoids, Verbascoside and Tenuifloroside from Castilleja tenuiflora Benth. Molecules 2019, 24, 1292. [Google Scholar] [CrossRef]
- Herrera-Ruiz, M.; López-Rodríguez, R.; Trejo-Tapia, G.; Domínguez-Mendoza, B.E.; González-Cortazar, M.; Tortoriello, J.; Zamilpa, A. A New Furofuran Lignan Diglycoside and Other Secondary Metabolites from the Antidepressant Extract of Castilleja tenuiflora Benth. Molecules 2015, 20, 13127–13143. [Google Scholar] [CrossRef]
- Fisher, M.C.; Henk, D.A.; Briggs, C.J.; Brownstein, J.S.; Madoff, L.C.; McCraw, S.L.; Gurr, S.J. Emerging fungal threats to animal, plant and ecosystem health. Nature 2012, 484, 186–194. [Google Scholar] [CrossRef]
- Loo, J.A. Ecological impacts of non-indigenous invasive fungi as forest pathogens. Biol. Invasions 2009, 11, 81–96. [Google Scholar] [CrossRef]
- Jan, R.; Asaf, S.; Numan, M.; Lubna; Kim, K.-M. Plant Secondary Metabolite Biosynthesis and Transcriptional Regulation in Response to Biotic and Abiotic Stress Conditions. Agronomy 2021, 11, 968. [Google Scholar] [CrossRef]
- Mikkelsen, B.L.; Olsen, C.E.; Lyngkjær, M.F. Accumulation of secondary metabolites in healthy and diseased barley, grown under future climate levels of CO2, ozone and temperature. Phytochemistry 2015, 118, 162–173. [Google Scholar] [CrossRef]
- Pavarini, D.P.; Pavarini, S.P.; Niehues, M.; Lopes, N.P. Exogenous influences on plant secondary metabolite levels. Anim. Feed. Sci. Technol. 2012, 176, 5–16. [Google Scholar] [CrossRef]
- Gallegos, H.L.; Cummins, G.B. Uredinales (Royas) de Mexico, Vol. 1; Instituto Nacional de Investigaciones Agricolas: Cualicán, Sinaloa, México, 1981. [Google Scholar]
- Holway, E.W.D.; Arthur, J.C. Uredinales of Guatemala Based on Collections by E. W. D. Holway. III. Puccinia, Exclusive of Species on Carduaceae. Am. J. Bot. 1918, 5, 462–489. [Google Scholar] [CrossRef]
- Berndt, R. A checklist of Costa Rican rust fungi. In Frontiers of Basidiomycote Mycology; Agerer, R.M.P., Blanz, P., Eds.; IHW: Eching, Germany, 2004; pp. 185–326. [Google Scholar]
- Hattab, Z.; Ben Lasfar, N.; Abid, M.; Bellazreg, F.; Fathallah, A.; Hachfi, W.; Letaief, A. Alternaria alternata infection causing rhinosinusitis and orbital involvement in an immunocompetent patient. New Microbes New Infect. 2019, 32, 100561. [Google Scholar] [CrossRef]
- Kim, G.; Yoo, S.J.; Yoo, J.R.; Seo, K.B. The first case report of thorn-induced Alternaria alternata infection of the hand in an immunocompetent host. BMC Infect. Dis. 2022, 22, 304. [Google Scholar] [CrossRef]
- Lawrence, D.P.; Rotondo, F.; Gannibal, P.B. Biodiversity and taxonomy of the pleomorphic genus Alternaria. Mycol. Prog. 2015, 15, 3. [Google Scholar] [CrossRef]
- Bessadat, N.; Hamon, B.; Bataillé-Simoneau, N.; Mabrouk, K.; Simoneau, P. Characterization of New Small-Spored Alternaria Species Isolated from Solanaceae in Algeria. Life 2021, 11, 1291. [Google Scholar] [CrossRef]
- Woudenberg, J.H.C.; Groenewald, J.Z.; Binder, M.; Crous, P.W. Alternaria redefined. Stud. Mycol. 2013, 75, 171–212. [Google Scholar] [CrossRef]
- Agrios, G.N. Plant Pathology, 5th ed.; Elsevier Academic Press: Cambridge, MA, USA, 2005. [Google Scholar]
- Simmons, E.G. Alternaria: An Identification Manual; CBS Fungal Biodiversity Centre: Utrecht, The Netherlands, 2007. [Google Scholar]
- Zervakis, G.; Philippoussis, A.; Ioannidou, S.; Diamantopoulou, P. Mycelium growth kinetics and optimal temperature conditions for the cultivation of edible mushroom species on lignocellulosic substrates. Folia Microbiol. 2001, 46, 231–234. [Google Scholar] [CrossRef]
- White, T.; Bruns, T.; Lee, S.; Taylor, J. Amplification and direct sequencing of fungal ribosomal RNA Genes for phylogenetics. In PCR Protocols, a Guide to Methods and Applications; Academic Press: Cambridge, MA, USA, 1990; pp. 315–322. [Google Scholar]
- Berbee, M.L.; Pirseyedi, M.; Hubbard, S. Cochliobolus phylogenetics and the origin of known, highly virulent pathogens, inferred from ITS and glyceraldehyde-3-phosphate dehydrogenase gene sequences. Mycologia 1999, 91, 964–977. [Google Scholar] [CrossRef]
- Sung, G.H.; Sung, J.M.; Hywel-Jones, N.L.; Spatafora, J.W. A multi-gene phylogeny of Clavicipitaceae (Ascomycota, Fungi): Identification of localized incongruence using a combinational bootstrap approach. Mol. Phylogenet. Evol. 2007, 44, 1204–1223. [Google Scholar] [CrossRef] [PubMed]
- Liu, Y.J.; Whelen, S.; Hall, B.D. Phylogenetic relationships among ascomycetes: Evidence from an RNA polymerse II subunit. Mol. Biol. Evol. 1999, 16, 1799–1808. [Google Scholar] [CrossRef] [PubMed]
- Carbone, I.; Kohn, L.M. A method for designing primer sets for speciation studies in filamentous ascomycetes. Mycologia 1999, 91, 553–556. [Google Scholar] [CrossRef]
- Okonechnikov, K.; Golosova, O.; Fursov, M. Unipro UGENE: A unified bioinformatics toolkit. Bioinformatics 2012, 28, 1166–1167. [Google Scholar] [CrossRef]
- Nilsson, R.H.; Kristiansson, E.; Ryberg, M.; Hallenberg, N.; Larsson, K.H. Intraspecific ITS variability in the kingdom fungi as expressed in the international sequence databases and its implications for molecular species identification. Evol. Bioinform. Online 2008, 4, 193–201. [Google Scholar] [CrossRef] [PubMed]
- Raja, H.A.; Miller, A.N.; Pearce, C.J.; Oberlies, N.H. Fungal Identification Using Molecular Tools: A Primer for the Natural Products Research Community. J. Nat. Prod. 2017, 80, 756–770. [Google Scholar] [CrossRef] [PubMed]
- Gouy, M.; Tannier, E.; Comte, N.; Parsons, D.P. Seaview Version 5: A Multiplatform Software for Multiple Sequence Alignment, Molecular Phylogenetic Analyses, and Tree Reconciliation. Methods Mol. Biol. 2021, 2231, 241–260. [Google Scholar] [CrossRef] [PubMed]
- Katoh, K.; Rozewicki, J.; Yamada, K.D. MAFFT online service: Multiple sequence alignment, interactive sequence choice and visualization. Brief. Bioinform. 2017, 20, 1160–1166. [Google Scholar] [CrossRef]
- Kumar, S.; Stecher, G.; Tamura, K. MEGA7: Molecular Evolutionary Genetics Analysis Version 7.0 for Bigger Datasets. Mol. Biol. Evol. 2016, 33, 1870–1874. [Google Scholar] [CrossRef] [PubMed]
- Maddison, W.P.; Maddison, D.R. Mesquite: A Modular System for Evolutionary Analysis. Version 3.7. 2023. Available online: https://mesquiteproject.org/ (accessed on 2 May 2024).
- Woudenberg, J.H.C.; Seidl, M.F.; Groenewald, J.Z.; de Vries, M.; Stielow, J.B.; Thomma, B.P.H.J.; Crous, P.W. Alternaria section Alternaria: Species, formae speciales or pathotypes? Stud. Mycol. 2015, 82, 1–21. [Google Scholar] [CrossRef]
- Edler, D.; Klein, J.; Antonelli, A.; Silvestro, D. raxmlGUI 2.0: A graphical interface and toolkit for phylogenetic analyses using RAxML. Methods Ecol. Evol. 2021, 12, 373–377. [Google Scholar] [CrossRef]
- Huelsenbeck, J.P.; Ronquist, F. MRBAYES: Bayesian inference of phylogenetic trees. Bioinformatics 2001, 17, 754–755. [Google Scholar] [CrossRef]
- Salcedo-Morales, G.; Rosas-Romero, G.; Nabor-Correa, N.; Bermúdez-Torres, K.; López-Laredo, A.R.; Trejo-Tapia, G. Propagation and conservation of Castilleja tenuiflora Benth. (“hierba del cancer”) through in vitro culture. Polibotánica 2009, 119–137. [Google Scholar]
- Ahmed, M.Z.; Saeed, S.; Hassan, A.; Ghuffar, S.; Abdullah, A.; Iqbal, R.; Anwaar, H.A.; Haque, K.; Asif, M.A.; Shafique, M.S. Alternaria alternata Causing Leaf Spot of Cucumis melo (Muskmelon) in Pakistan. Plant Dis. 2021, 105, 1853. [Google Scholar] [CrossRef] [PubMed]
- Maiti, C.K.; Sen, S.; Paul, A.K.; Acharya, K. First Report of Alternaria dianthicola Causing Leaf Blight on Withania somnifera from India. Plant Dis. 2007, 91, 467. [Google Scholar] [CrossRef]
- Praveen, B.; Nagaraja, A.; Prasanna Kumar, M.K.; Pramesh, D.; Palanna, K.B.; Buella, P.P. First Report of Alternaria alternata Causing Leaf Blight on Little Millet (Panicum sumatrense) in India. Plant Dis. 2021, 105, 1202. [Google Scholar] [CrossRef]
- Schmey, T.; Tominello-Ramirez, C.S.; Brune, C.; Stam, R. Alternaria diseases on potato and tomato. Mol. Plant Pathol. 2024, 25, e13435. [Google Scholar] [CrossRef]
- Luo, M.; Zhao, M.; Huang, Y.; Liu, J.; Huang, Q.; Shu, Y.; Dong, Z. First Record of Alternaria pogostemonis: A Novel Species Causing Leaf Spots in Pogostemon cablin. Pathogens 2022, 11, 1105. [Google Scholar] [CrossRef]
- Oliver, R.P. Agrios’ Plant Pathology, 6th ed.; Elsevier: London, UK, 2024. [Google Scholar]
- Visconti, V.; Rigalma, K.; Coton, E.; Dantigny, P. Impact of the physiological state of fungal spores on their inactivation by active chlorine and hydrogen peroxide. Food Microbiol. 2021, 100, 103850. [Google Scholar] [CrossRef] [PubMed]
- Pereira, V.J.; Marques, R.; Marques, M.; Benoliel, M.J.; Barreto Crespo, M.T. Free chlorine inactivation of fungi in drinking water sources. Water Res. 2013, 47, 517–523. [Google Scholar] [CrossRef] [PubMed]
- Shao, H.; Chu, L.; Jaleel, C.; Zhao, C. Water-deficit stress-induced anatomical changes in higher plants. Comptes Rendus Biol. 2008, 331, 215–225. [Google Scholar] [CrossRef] [PubMed]
- Logrieco, A.F.; Moretti, A.; Solfrizzo, M. Alternaria toxins and plant diseases: An overview of origin, occurrence and risks. World Mycotoxin J. 2009, 2, 129–140. [Google Scholar] [CrossRef]
- Achilonu, C.C.; Marais, G.J.; Ghosh, S.; Gryzenhout, M. Multigene Phylogeny and Pathogenicity Trials Revealed Alternaria alternata as the Causal Agent of Black Spot Disease and Seedling Wilt of Pecan (Carya illinoinensis) in South Africa. Pathogens 2023, 12, 672. [Google Scholar] [CrossRef]
- Dettman, J.R.; Eggertson, Q. Phylogenomic analyses of Alternaria section Alternaria: A high-resolution, genome-wide study of lineage sorting and gene tree discordance. Mycologia 2021, 113, 1218–1232. [Google Scholar] [CrossRef] [PubMed]
- Wu, B.; Hussain, M.; Zhang, W.; Stadler, M.; Liu, X.; Xiang, M. Current insights into fungal species diversity and perspective on naming the environmental DNA sequences of fungi. Mycology 2019, 10, 127–140. [Google Scholar] [CrossRef]
- Adhikari, T.B.; Muzhinji, N.; Halterman, D.; Louws, F.J. Genetic diversity and population structure of Alternaria species from tomato and potato in North Carolina and Wisconsin. Sci. Rep. 2021, 11, 17024. [Google Scholar] [CrossRef]
- Akhtar, K.P.; Saleem, M.Y.; Asghar, M.; Haq, M.A. New report of Alternaria alternata causing leaf blight of tomato in Pakistan. Plant Pathol. 2004, 53, 816. [Google Scholar] [CrossRef]
- Gou, Y.; Aung, S.L.L.; Guo, Z.; Li, Z.; Shen, S.; Deng, J. Four New Species of Small-Spored Alternaria Isolated from Solanum tuberosum and S. lycopersicum in China. J. Fungi 2023, 9, 880. [Google Scholar] [CrossRef]
- Abbasi, P.A.; Ali, S.; Renderos, W.; Naeem, H.A.; Papadopoulos, Y. First report of Alternaria alternata causing leaf spot and blight symptoms on alfalfa in Canada. Can. J. Plant Pathol. 2018, 40, 451–455. [Google Scholar] [CrossRef]
- Mohamed, O.E.; Beshir, M.M.; Ahmed, N.E. Cotton leaf blight disease caused by Alternaria alternata in Sudan. J. Plant Prot. Res. 2019, 59, 412–417. [Google Scholar] [CrossRef]
- Nira, S.T.; Hossain, M.F.; Mahmud, N.U.; Hassan, O.; Islam, T.; Akanda, A.M. Alternaria leaf spot of broccoli caused by Alternaria alternata in Bangladesh. Plant Prot. Sci. 2022, 58, 49–56. [Google Scholar] [CrossRef]
- Hopkins, J.C.F. Alternaria gossypina (Thüm.) comb. nov. causing a leaf spot and boll rot of cotton. Trans. Br. Mycol. Soc. 1931, 16, 136–144. [Google Scholar] [CrossRef]
- Montiel-Salero, D.; Jiménez-Aguilar, A.; Ramírez-Sánchez, S.; Ruiz-Juárez, D.; Guerrero-Andrade, O.; Segundo-Pedraza, E.; Olivares-Orozco, J.; Ramos-López, M.; Flores-Macías, A. First report of Alternaria alternata causing the golden spot in xoconostle (Opuntia matudae) in Hidalgo, México. Mex. J. Phytopathol. 2022, 40, 131–144. [Google Scholar] [CrossRef]
- Arratia-Castro, A.A.; Fernández-Herrera, E.; Gómez-Espinoza, M.G.; Herrera-Flores, T.S.; Moreno-Contreras, M.G.; Licea-de Anda, E.M.; Ramírez-Bustos, I.I. Alternaria alternata, Fusarium oxysporum and Fusarium verticillioides identified as causal agents of broccoli head rot in Mexico. Rev. Chapingo Ser. Hortic. 2022, 28, 175–188. [Google Scholar] [CrossRef]
- Reyes-Tena, A.; Montoya-Martínez, A.C.; Fernández-Pavía, S.P.; Santillán-Mendoza, R.; Jiménez-Villegas, A.; Pineda-Vaca, D.; Rodríguez-Alvarado, G. Onion leaf blight caused by Alternaria alternata sensu lato and Stemphylium vesicarium in Michoacán, México. Can. J. Plant Pathol. 2024, 46, 79–88. [Google Scholar] [CrossRef]
- Li, Y.X.; Dong, X.F.; Yang, A.L.; Zhang, H.B. Diversity and pathogenicity of Alternaria species associated with the invasive plant Ageratina adenophora and local plants. PeerJ 2022, 10, e13012. [Google Scholar] [CrossRef]
- Baltzakis, I.; Nindya, S.; Rahmayani, R.; Thomas, J.E.; van der Werf, W.; Struik, P.C. Pathogenicity of Single and Combined Inoculations of Alternaria spp. on Potato. Potato Res. 2024. [Google Scholar] [CrossRef]
- Ismail, A.M.; Elshewy, E.S.; El-Ganainy, S.M.; Magistà, D.; Hamouda, A.F.; Alhudaib, K.A.; Ebrahim, W.; Almaghasla, M.I. Mycotoxins from Tomato Pathogenic Alternaria alternata and Their Combined Cytotoxic Effects on Human Cell Lines and Male Albino Rats. J. Fungi 2023, 9, 282. [Google Scholar] [CrossRef]
- Rudawska, M.; Leski, T.; Stasińska, M.; Karliński, L.; Wilgan, R.; Kujawska, M. The contribution of forest reserves and managed forests to the diversity of macrofungi of different trophic groups in European mixed coniferous forest ecosystem. For. Ecol. Manag. 2022, 518, 120274. [Google Scholar] [CrossRef]
- Cibrián-Tovar, D.; Alvarado-Rosales, D.; García-Díaz, S.E. Enfermedades Forestales en México; Universidad Autónoma Chapingo: Texcoco, Mexico, 2007. [Google Scholar]

| Species | Isolate Code | ITS | gapdh | rpb2 | tef1 |
|---|---|---|---|---|---|
| Alternaria alstroemeriae | CBS 118808 | KP124296 | KP124153 | KP124764 | KP125071 |
| CBS 118809 | KP124297 | KP124154 | KP124765 | KP125072 | |
| Alternaria alternata | CBS 106.24 | KP124298 | KP124155 | KP124766 | KP125073 |
| CBS 103.33 | KP124302 | KP124159 | KP124770 | KP125077 | |
| CBS 117.44 | KP124303 | KP124160 | KP124772 | KP125079 | |
| CBS 102.47 | KP124304 | KP124161 | KP124773 | KP125080 | |
| CBS 194.86 | KP124316 | KP124172 | KP124784 | KP125092 | |
| CBS 195.86 | KP124317 | KP124173 | KP124785 | KP125093 | |
| CBS 479.90 | KP124319 | KP124174 | KP124787 | KP125095 | |
| CBS 595.93 | KP124320 | KP124175 | KP124788 | KP125096 | |
| CBS 918.96 | AF347032 | AY278809 | KC584435 | KC584693 | |
| CBS 102598 | KP124329 | KP124184 | KP124797 | KP125105 | |
| CBS 110977 | AF347031 | AY278808 | KC584375 | KC584634 | |
| CBS 118811 | KP124356 | KP124210 | KP124824 | KP125132 | |
| CBS 118812 | KC584193 | KC584112 | KC584393 | KC584652 | |
| CBS 118814 | KP124357 | KP124211 | KP124825 | KP125133 | |
| CBS 118818 | KP124359 | KP124213 | KP124827 | KP125135 | |
| CBS 121336 | KJ862254 | KJ862255 | KP124833 | KP125141 | |
| CBS 121348 | KP124367 | KP124219 | KP124836 | KP125144 | |
| CBS 121454 | MH863109 | AY278812 | KP124837 | KP125145 | |
| CBS 127672 | KP124382 | KP124234 | KP124852 | KP125160 | |
| IPN 10.0152 | PP099883 | PP354051 | PP354054 | PP354057 | |
| IPN 10.0153 | PP099884 | PP354052 | PP354055 | PP354058 | |
| Alternaria arborescens | CBS 101.13 | KP124392 | KP124244 | KP124862 | KP125170 |
| CBS 105.24 | KP124393 | KP124245 | KP124863 | KP125171 | |
| CBS 102605 | AF347033 | AY278810 | KC584377 | KC584636 | |
| CBS 750.68 | KP124398 | KP124250 | KP124868 | KP125176 | |
| CBS 118389 | KP124407 | KP124259 | KP124877 | KP125185 | |
| CBS 119544 | KP124408 | JQ646321 | KP124878 | KP125186 | |
| CBS 119545 | KP124409 | KP124260 | KP124879 | KP125187 | |
| Alternaria betae-kenyensis | CBS 118810 | KP124419 | KP124270 | KP124888 | KP125197 |
| Alternaria burnsii | CBS 108.27 | KC584236 | KC584162 | KC584468 | KC584727 |
| CBS 107.38 | KP124420 | JQ646305 | KP124889 | KP125198 | |
| CBS 110.50 | KP124421 | KP124271 | KP124890 | KP125199 | |
| CBS 879.95 | KP124422 | KP124272 | KP124891 | KP125200 | |
| CBS 118816 | KP124423 | KP124273 | KP124892 | KP125201 | |
| CBS 118817 | KP124424 | KP124274 | KP124893 | KP125202 | |
| Alternaria eichhorniae | CBS 489.92 | KC146356 | KP124276 | KP124895 | KP125204 |
| CBS 119778 | KP124426 | KP124277 | KP124896 | KP125205 | |
| Alternaria gaisen | CBS 632.93 | KC584197 | KC584116 | KC584399 | KC584658 |
| CBS 118488 | KP124427 | KP124278 | KP124897 | KP125206 | |
| CPC 25268 | KP124428 | KP124279 | KP124898 | KP125207 | |
| Alternaria gossypina | CBS 100.23 | KP124429 | KP124280 | KP124899 | KP125208 |
| CBS 104.32 | KP124430 | JQ646312 | KP124900 | KP125209 | |
| CBS 107.36 | KP124431 | JQ646310 | KP124901 | KP125210 | |
| CBS 102597 | KP124432 | KP124281 | KP124902 | KP125211 | |
| CBS 102601 | KP124433 | KP124282 | KP124903 | KP125212 | |
| IPN 10.0151 | PP099882 | PP354050 | PP354053 | PP354056 | |
| Alternaria iridiaustralis | CBS 118404 | KP124434 | KP124283 | KP124904 | KP125213 |
| CBS 118486 | KP124435 | KP124284 | KP124905 | KP125214 | |
| CBS 118487 | KP124436 | KP124285 | KP124906 | KP125215 | |
| Alternaria jacinthicola | CBS 878.95 | KP124437 | KP124286 | KP124907 | KP125216 |
| CBS 133751 | KP124438 | KP124287 | KP124908 | KP125217 | |
| CPC 25267 | KP124439 | KP124288 | KP124909 | KP125218 | |
| Alternaria longipes | CBS 113.35 | KP124440 | KP124289 | KP124910 | KP125219 |
| CBS 539.94 | KP124441 | KP124290 | KP124911 | KP125220 | |
| CBS 540.94 | AY278835 | AY278811 | KC584409 | KC584667 | |
| CBS 917.96 | KP124442 | KP124291 | KP124912 | KP125221 | |
| CBS 121332 | KP124443 | KP124292 | KP124913 | KP125222 | |
| CBS 121333 | KP124444 | KP124293 | KP124914 | KP125223 | |
| Alternaria tomato | CBS 103.30 | KP124445 | KP124294 | KP124915 | KP125224 |
| CBS 114.35 | KP124446 | KP124295 | KP124916 | KP125225 | |
| Alternaria alternantherae | CBS 124392 | KC584179 | KC584096 | KC584374 | KC584633 |
Disclaimer/Publisher’s Note: The statements, opinions and data contained in all publications are solely those of the individual author(s) and contributor(s) and not of MDPI and/or the editor(s). MDPI and/or the editor(s) disclaim responsibility for any injury to people or property resulting from any ideas, methods, instructions or products referred to in the content. |
© 2024 by the authors. Licensee MDPI, Basel, Switzerland. This article is an open access article distributed under the terms and conditions of the Creative Commons Attribution (CC BY) license (https://creativecommons.org/licenses/by/4.0/).
Share and Cite
Solano-Báez, A.R.; Trejo-Tapia, G.; Kolařík, M.; Ortiz-Álvarez, J.; Trejo-Espino, J.L.; Márquez-Licona, G. Etiology of Foliar Blight of Indian Paintbrush (Castilleja tenuiflora) in Mexico. Microorganisms 2024, 12, 1714. https://doi.org/10.3390/microorganisms12081714
Solano-Báez AR, Trejo-Tapia G, Kolařík M, Ortiz-Álvarez J, Trejo-Espino JL, Márquez-Licona G. Etiology of Foliar Blight of Indian Paintbrush (Castilleja tenuiflora) in Mexico. Microorganisms. 2024; 12(8):1714. https://doi.org/10.3390/microorganisms12081714
Chicago/Turabian StyleSolano-Báez, Alma Rosa, Gabriela Trejo-Tapia, Miroslav Kolařík, Jossue Ortiz-Álvarez, José Luis Trejo-Espino, and Guillermo Márquez-Licona. 2024. "Etiology of Foliar Blight of Indian Paintbrush (Castilleja tenuiflora) in Mexico" Microorganisms 12, no. 8: 1714. https://doi.org/10.3390/microorganisms12081714
APA StyleSolano-Báez, A. R., Trejo-Tapia, G., Kolařík, M., Ortiz-Álvarez, J., Trejo-Espino, J. L., & Márquez-Licona, G. (2024). Etiology of Foliar Blight of Indian Paintbrush (Castilleja tenuiflora) in Mexico. Microorganisms, 12(8), 1714. https://doi.org/10.3390/microorganisms12081714

